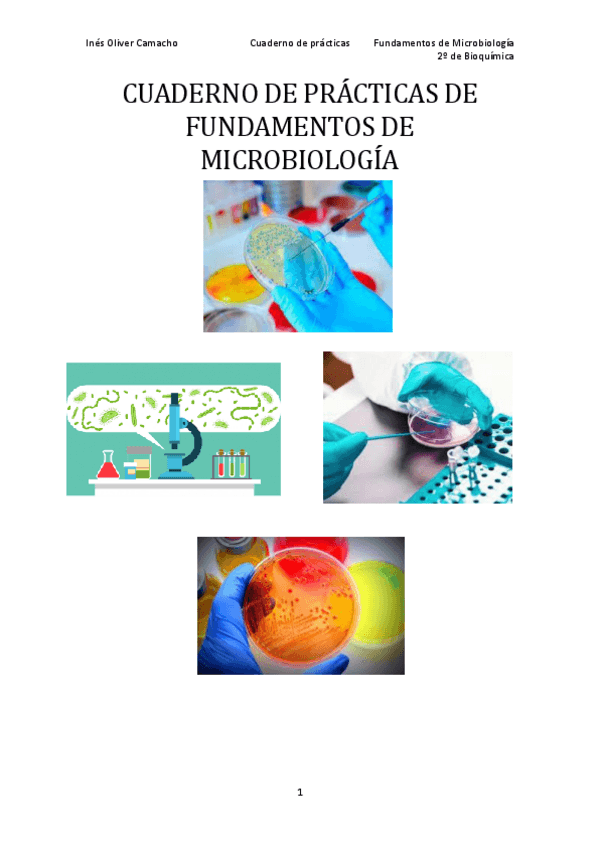

Fundamentos de Microbiología
He publicado nuevos apuntes de 2º Fundamentos de Microbiología: Resumen-Reacciones-Quimicas-FMi.pdf
apuntes
-
APUNTES COMPLETOS 1-9
He publicado nuevos apuntes de 2º Fundamentos de Microbiología: APUNTES COMPLETOS 1-9
He publicado nuevos apuntes de 2º Fundamentos de Microbiología: microbiologia.pdf
He publicado nuevos apuntes de 2º Fundamentos de Microbiología: RESUMEN-TEMA-4-con-tablas.pdf
He publicado nuevos apuntes de 2º Fundamentos de Microbiología: IntroduccionalaMicrobiologia.pdf
He publicado nuevos apuntes de 2º Fundamentos de Microbiología: Tema 9 Mecanismos de transferencia genética.pdf
He publicado nuevos apuntes de 2º Fundamentos de Microbiología: Tema 8 Variaciones geneticas explicadas.pdf
apuntes
-
Apuntes completos
He publicado nuevos apuntes de 2º Fundamentos de Microbiología: Apuntes completos
He publicado nuevos practicas de 2º Fundamentos de Microbiología: Cuaderno-de-practicas.pdf
apuntes
-
Apuntes
He publicado nuevos apuntes de 2º Fundamentos de Microbiología: Apuntes
apuntes
-
Apuntes Microbiología
He publicado nuevos apuntes de 2º Fundamentos de Microbiología: Apuntes Microbiología
apuntes
-
Temas del 3 al 12
He publicado nuevos apuntes de 2º Fundamentos de Microbiología: Temas del 3 al 12
apuntes
-
Apuntes Microbiología
He publicado nuevos apuntes de 2º Fundamentos de Microbiología: Apuntes Microbiología
apuntes
-
Esquemas T4
He publicado nuevos apuntes de 2º Fundamentos de Microbiología: Esquemas T4
He publicado nuevos examenes de 2º Fundamentos de Microbiología: Pruebas-Micro.pdf
He publicado nuevos practicas de 2º Fundamentos de Microbiología: cuaderno-practicas-microbiologia.pdf
He publicado nuevos practicas de 2º Fundamentos de Microbiología: CUADERNO-DE-PRACTICAS-MICROBIOLOGIA-1.pdf
practicas
-
Prácticas
He publicado nuevos practicas de 2º Fundamentos de Microbiología: Prácticas
apuntes
-
Apuntes
He publicado nuevos apuntes de 2º Fundamentos de Microbiología: Apuntes
He publicado nuevos examenes de 2º Fundamentos de Microbiología: examen-enero-2020.pdf
He publicado nuevos examenes de 2º Fundamentos de Microbiología: Documento.pdf
He publicado nuevos apuntes de 2º Fundamentos de Microbiología: Tema-6-Crecimiento-microbiano.pdf
He publicado nuevos apuntes de 2º Fundamentos de Microbiología: TEMA-5-NUTRICION-EN-PROCARIOTAS.pdf
He publicado nuevos apuntes de 2º Fundamentos de Microbiología: TEMA-4-METABOLISMO-ENERGETICO-EN-PROCARIOTAS.pdf
He publicado nuevos apuntes de 2º Fundamentos de Microbiología: TEMA-3-ESTRUCTURA-GENERAL-DE-LA-CELULA-PROCARIOTA.pdf
He publicado nuevos examenes de 2º Fundamentos de Microbiología: 2o-parcial.pdf
He publicado nuevos examenes de 2º Fundamentos de Microbiología: 2o-PARCIAL-FUNDAMENTOS-MICROBIOLOGIA-18-19.pdf
He publicado nuevos examenes de 2º Fundamentos de Microbiología: 2o-parcial-2016-2017.pdf
He publicado nuevos apuntes de 2º Fundamentos de Microbiología: 1a-prueba-microbiologia-19-20.docx
He publicado nuevos apuntes de 2º Fundamentos de Microbiología: EXAMEN-PARCIAL-RESUELTO.pdf
He publicado nuevos apuntes de 2º Fundamentos de Microbiología: EXAMEN-2016-RESUELTO-1.pdf
ejercicios
-
Exámenes y cuaderno de prácticas
He publicado nuevos ejercicios de 2º Fundamentos de Microbiología: Exámenes y cuaderno de prácticas
apuntes
-
Apuntes microbiología
Faltan el tema 10, y el tema 11 que es de seminario
examenes
-
Exámenes de Cursos Anteriores
Exámenes de Maqueda de años anteriores. El primer y segundo parcial del curso 2016/2017 están completos. Los documentos que no tienen el curso indicado tienen algunas de las preguntas que hizo en exámenes de cursos anteriores al 2016/2017.
apuntes
-
Apuntes Micro
He publicado nuevos apuntes de 2º Fundamentos de Microbiología: Apuntes Micro
He publicado nuevos apuntes de 2º Fundamentos de Microbiología: Microbiología.Tema 1.pdf

¡Estás al día!
Has visto todos los archivos